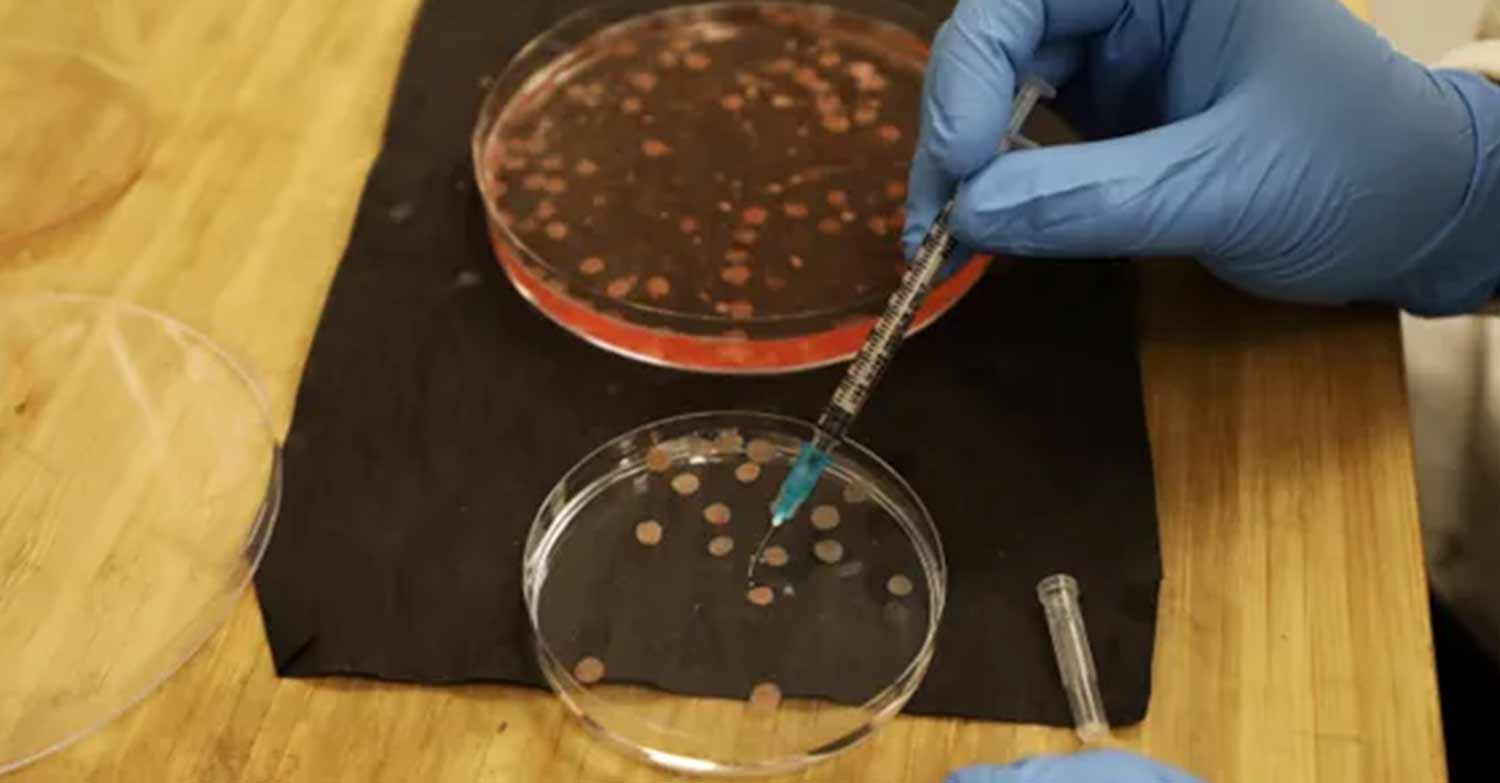

Το πανεπιστημιακό ιατρικό κέντρο Hadassah της Ιερουσαλήμ στο Ισραήλ ανακοίνωσε την Τρίτη (30/5) ένα «άνευ προηγουμένου επίτευγμα» στη θεραπεία του καρκίνου του πολλαπλού μυελώματος – της δεύτερης πιο συχνής αιματολογικής νόσου, που αντιπροσωπεύει το 1/10 όλων των καρκίνων του αίματος και το 1% όλων των τύπων κακοηθειών.
Η καινοτόμος θεραπεία κατά της νόσου, η οποία εδώ και καιρό θεωρείται ανίατη, αναπτύχθηκε μετά από μια σειρά πειραμάτων που πραγματοποιήθηκαν στο τμήμα μεταμόσχευσης μυελού των οστών και ανοσοθεραπείας του νοσοκομείου τα τελευταία χρόνια, σύμφωνα με σχετικό δημοσίευμα της Jerusalem Post.

«Έχουμε μια λίστα αναμονής με πάνω από 200 ασθενείς από το Ισραήλ και διάφορα μέρη του κόσμου ανά πάσα στιγμή. Τώρα, υπό το φως των εντυπωσιακών αποτελεσμάτων των θεραπειών CAR-T, φαίνεται ότι έχουν πολλά ακόμη χρόνια ζωής – και με εξαιρετική ποιότητα ζωής», δήλωσε η επικεφαλής του τμήματος, καθηγήτρια Πολίνα Στεπένσκι.
Η θεραπεία βασίζεται στην τεχνολογία γενετικής μηχανικής, η οποία είναι μια αποτελεσματική και πρωτοποριακή λύση για ασθενείς με προσδόκιμο ζωής μόλις δύο έτη μέχρι πριν από λίγα χρόνια. Ειδικότερα, έχει χρησιμοποιηθεί μια τεχνολογία γενετικής μηχανικής που ονομάζεται CAR-T, ή Χιμαιρικός Αντιγονικός Υποδοχέας Τ-κυττάρων, η οποία ενισχύει το ανοσοποιητικό σύστημα του ίδιου του ασθενούς για να καταστρέψει τον καρκίνο. Περισσότερο από το 90% των 74 ασθενών που υποβλήθηκαν σε θεραπεία στο Hadassah παρουσίασαν «πλήρη απαλλαγή», σύμφωνα με τους ογκολόγους.
Λόγω της πολυπλοκότητας της θεραπείας, ωστόσο, μόνο ένας ασθενής την εβδομάδα εισέρχεται στη θεραπεία, η οποία εξακολουθεί να διεξάγεται ως πείραμα.
«Εχουμε στοιχεία για ένα πολύ θετικό συνολικό ποσοστό ανταπόκρισης με ελάχιστες παρενέργειες και ήπιες», εξήγησε η Στεπένσκι. «Αυτή είναι μια τεράστια ελπίδα για ασθενείς με μια ασθένεια που δεν έχει ακόμη θεραπευτεί», πρόσθεσε.
Η πειραματική θεραπεία θα παρέχεται επίσης σε όλες τις ΗΠΑ τους επόμενους μήνες.

Τι είναι το πολλαπλό μυέλωμα
Το πολλαπλό μυέλωμα είναι ένας τύπος καρκίνου του μυελού των οστών, ο οποίος είναι ο σπογγώδης ιστός στο κέντρο ορισμένων οστών που παράγει τα αιμοσφαίρια του σώματος. Η ασθένεια ονομάστηκε πολλαπλό μυέλωμα επειδή ο καρκίνος συχνά επηρεάζει πολλές περιοχές του σώματος, συμπεριλαμβανομένου του κρανίου, της λεκάνης, των πλευρών και της σπονδυλικής στήλης. Πολλές φορές διαγιγνώσκεται μετά από εξέταση αίματος ή ούρων ρουτίνας.
Στην αρχή, μπορεί να μην προκαλεί κανένα σύμπτωμα, αλλά καθώς αναπτύσσεται, το μυέλωμα προκαλεί μια μεγάλη ποικιλία προβλημάτων, συμπεριλαμβανομένου του χρόνιου πόνου στα οστά, αδυναμία, δύσπνοια και κόπωση που προκύπτει από αναιμία, υψηλά επίπεδα ασβεστίου στο αίμα που μπορεί να προκαλέσουν άλλα συμπτώματα, όπως υπερβολική δίψα, πόνο στο στομάχι, ανάγκη για συχνή ούρηση, σύγχυση και δυσκοιλιότητα, απώλεια βάρους, ζάλη, θολή όραση και πονοκεφάλους, επαναλαμβανόμενες λοιμώξεις, μώλωπες και ασυνήθιστη αιμορραγία, αδύναμα οστά που σπάνε εύκολα και προβλήματα στα νεφρά.
Η νόσος είναι πιο συχνή σε άτομα ηλικίας άνω των 60 ετών. Συνήθως διαγιγνώσκεται μετά την ηλικία των 70 ετών και σπάνια κάτω των 40 ετών, στους άνδρες περισσότερο από τις γυναίκες και σε άτομα με οικογενειακό ιστορικό πολλαπλού μυελώματος.
Μέχρι τώρα, η εν λόγω θεραπεία ήταν διαθέσιμη μόνο στην Κίνα και τις ΗΠΑ έναντι σχεδόν 400.000 δολαρίων ανά θεραπεία ασθενούς και είναι πολύ περιορισμένη στη διαθεσιμότητά της.
«Μόνο το 20% όσων πρέπει να τη λάβουν σε αυτές τις χώρες τη λαμβάνουν στην πραγματικότητα», σύμφωνα με τη Στεπένσκι. Η ίδια τονίζει ότι το Hadassah ανέπτυξε μια πιο εξελιγμένη και προηγμένη θεραπεία από αυτή που προσφέρεται μέχρι σήμερα στον κόσμο.
Πηγή: Jerusalem Post